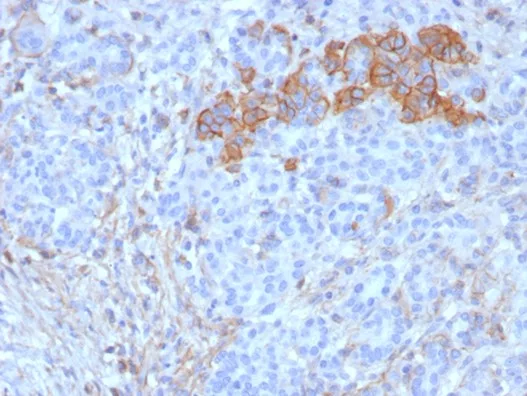

Formalin-fixed, paraffin-embedded human pancreas stained with CD99 Recombinant Mouse Monoclonal Antibody (rMIC2/6939). Inset: PBS instead of primary antibody; secondary only negative control.
Formalin-fixed, paraffin-embedded human pancreas stained with CD99 Recombinant Mouse Monoclonal Antibody (rMIC2/6939). HIER: Tris/EDTA, pH9.0, 45min. 2°C: HRP-polymer, 30min. DAB, 5min.
Recognizes a sialoglycoprotein of 27-32kDa, identified as CD99, or MIC2 gene product, or E2 antigen. MIC2 gene is located in the pseudo-autosomal region of the human X and Y chromosome. MIC2 gene encodes two distinct proteins, which are produced by alternative splicing of the CD99 gene transcript and are identified as bands of 30 and 32kDa (p30/32). �Although its function is not fully understood, CD99 is implicated in various cellular processes including homotypic aggregation of T cells, upregulation of T cell receptor and MHS molecules, apoptosis of immature thymocytes and leukocyte diapedesis. �CD99 is expressed on the cell membrane of some lymphocytes, cortical thymocytes, and granulosa cells of the ovary. Most pancreatic islet cells, Sertoli cells of the testis, and some endothelial cells express this antigen. Mature granulocytes express very little or no CD99. MIC2 is strongly expressed on Ewing s sarcoma cells and primitive peripheral neuroectodermal tumors.
There are no reviews yet.